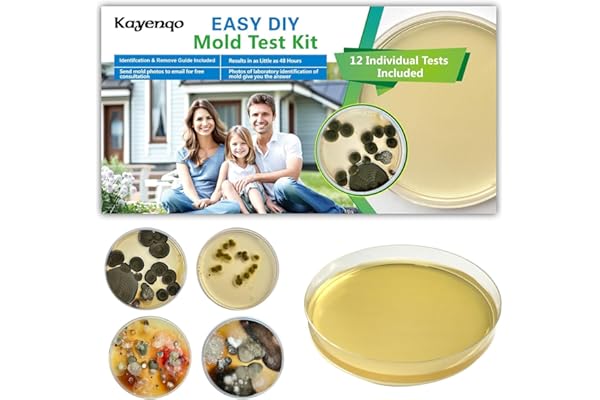
Mold Test Kit for Home - 12 Simple Detection Tests,Test HVAC System,Home Surfaces,& Indoor Air Quality Testing Kits,DIY Mold

Corey
Decent endoscope…and affordable
{“clickstreamNexusMetricsConfig”:{“actionType”:”DISCOVERY”,”producerId”:”vsemetrics_playercards”,”eventType”:”IVEVideoView”,”productId”:””,”eventOwner”:”vsemetrics_playercards”,”schemaId”:”clickstream.CustomerEvent.4″},”clientPrefix”:”vse_reviews_desktop_rzptu3wkr26f4_1763370687598″,”ccvDisclosure”:””,”closedCaptionsConfig”:{“captionsOnTexts”:{“de”:”German (Automated)”,”en”:”English (Automated)”,”fr”:”French (Automated)”,”es”:”Spanish (Automated)”},”captionsOffText”:”Captions off”,”languageToLabelTexts”:{“English”:”English”,”German”:”German”,”Spanish”:”Spanish”,”French”:”French”}},”sushiMetricsConfig”:{“isRobot”:false,”clientId”:”VSE-US”,”videoAsinList”:””,”weblabIds”:””,”eventSource”:”Player”,”sessionId”:”142-1849299-0382426″,”refMarkers”:”vse_reviews_desktop_RZPTU3WKR26F4_1763370687598_ref”,”placementContext”:”cr_inline_review”,”marketplaceId”:”ATVPDKIKX0DER”,”isInternal”:false,”endpoint”:”https://unagi-na.amazon.com/1/events/com.amazon.eel.vse.metrics.prod.events.test”,”requestId”:”J81QYDQ23EVRM4N5STYP”,”customerId”:”A2K2W4MTZROM02″,”sessionType”:1},”mimeType”:”application/x-mpegURL”,”reportUrl”:””,”nexusMetricsConfig”:{“isInternal”:false,”widgetMetricsSchemaId”:”vse.VSECardsEvents.9″,”clientId”:”VSE-US”,”videoAsinList”:””,”weblabIds”:””,”eventSource”:”Player”,”videoAsin”:”RZPTU3WKR26F4″,”customerId”:”A2K2W4MTZROM02″,”producerId”:”vsemetrics_playercards”,”refMarkers”:”vse_reviews_desktop_RZPTU3WKR26F4_1763370687598_ref”,”placementContext”:”cr_inline_review”,”playerTSMMetricsSchemaId”:”vse.VSECardsPlayerEvents.9″},”videoHeight”:0,”videoWidth”:0,”initialClosedCaptions”:”en,https://m.media-amazon.com/images/S/vse-vms-closed-captions-artifact-us-east-1-prod/closedCaptions/1b09f373-be71-4018-8032-a4375f8e50f2.vtt”,”eligibleToTriggerCCWeblab”:false,”videoUrl”:”https://m.media-amazon.com/images/S/vse-vms-transcoding-artifact-us-east-1-prod/481e54c8-8cab-4fd7-abca-0c7c00c6ff49/embedded.cc.default.vertical.jobtemplate.hls.m3u8″,”metricsEmissionMethod”:”nexus”,”imageUrl”:”https://m.media-amazon.com/images/I/418aaTrI1KL._SY256.jpg”,”awaConfig”:{“useUpNextComponent”:false,”clickstreamNexusMetricsConfig”:{“actionType”:”DISCOVERY”,”producerId”:”vsemetrics_playercards”,”eventType”:”IVEVideoView”,”productId”:””,”eventOwner”:”vsemetrics_playercards”,”schemaId”:”clickstream.CustomerEvent.4″},”initialVideo”:”RZPTU3WKR26F4″,”shouldPreload”:true,”enableClickBasedAttribution”:false,”isChromelessPlayer”:false,”closedCaptionsConfig”:{“captionsOnTexts”:{“de”:”German (Automated)”,”en”:”English (Automated)”,”fr”:”French (Automated)”,”es”:”Spanish (Automated)”},”captionsOffText”:”Captions off”,”languageToLabelTexts”:{“English”:”English”,”German”:”German”,”Spanish”:”Spanish”,”French”:”French”}},”enableDynamicBlur”:false,”showPlayerPlayButton”:false,”isVideoImmersivePlayer”:false,”metricsEmissionMethod”:”nexus”,”skipInitialFocus”:false,”playerSkin”:”none”,”disabledViewIds”:[“replayHint”],”includeEarnsComissionDisclosure”:false,”customerId”:”A2K2W4MTZROM02″,”containerId”:”vse_reviews_desktop_rzptu3wkr26f4_1763370687598-player-340993d6-2730-4991-8fb0-8493b861c8d2″,”allowCrossOrigin”:false,”requestMetadata”:{“marketplaceId”:”ATVPDKIKX0DER”,”clientId”:”VSE-US”,”sessionId”:”142-1849299-0382426″,”method”:”cr_inline_review”,”requestId”:”J81QYDQ23EVRM4N5STYP”,”pageAsin”:””},”shouldLoop”:false,”shouldDisableControls”:false,”alwaysSetInitialVideo”:true,”showPlayerCloseButton”:false,”clientPrefix”:””,”useAutoplayFallback”:false,”sushiMetricsConfig”:{“isRobot”:false,”clientId”:”VSE-US”,”videoAsinList”:””,”weblabIds”:””,”eventSource”:”Player”,”sessionId”:”142-1849299-0382426″,”refMarkers”:”vse_reviews_desktop_RZPTU3WKR26F4_1763370687598_ref”,”placementContext”:”cr_inline_review”,”marketplaceId”:”ATVPDKIKX0DER”,”isInternal”:false,”endpoint”:”https://unagi-na.amazon.com/1/events/com.amazon.eel.vse.metrics.prod.events.test”,”requestId”:”J81QYDQ23EVRM4N5STYP”,”customerId”:”A2K2W4MTZROM02″,”sessionType”:1},”ospLinkCode”:””,”showPosterImage”:true,”languageCode”:”en”,”languageLocalization”:{“play”:”Play”,”volumeLevel”:”Volume Level”,”subtitles”:”Subtitles”,”volumeSlider”:”Volume Slider”,”playVideo”:”Click to play video”,”fullscreen”:”Fullscreen”,”scrubberBar”:”Scrubber bar”,”mute”:”Mute”,”unmute”:”Unmute”,”pause”:”Pause”,”captions”:”Captions”,”nonfullscreen”:”Non-Fullscreen”},”version”:””,”isMoreVideosButtonEnabled”:false,”nexusMetricsConfig”:{“isInternal”:false,”widgetMetricsSchemaId”:”vse.VSECardsEvents.9″,”clientId”:”VSE-US”,”videoAsinList”:””,”weblabIds”:””,”eventSource”:”Player”,”videoAsin”:”RZPTU3WKR26F4″,”customerId”:”A2K2W4MTZROM02″,”producerId”:”vsemetrics_playercards”,”refMarkers”:”vse_reviews_desktop_RZPTU3WKR26F4_1763370687598_ref”,”placementContext”:”cr_inline_review”,”playerTSMMetricsSchemaId”:”vse.VSECardsPlayerEvents.9″},”shouldStartMuted”:false,”airyVersion”:”VideoJS”,”languagePreferenceStrings”:{},”enableInactiveFocus”:true,”isReactFactory”:false,”enableDelphiAttribution”:false,”includeReportWidget”:false,”shouldAutoplay”:false},”needPlayerFactory”:false,”isMobile”:false}The video showcases the product in use.The video guides you through product setup.The video compares multiple products.The video shows the product being unpacked.Video Player is loading.Click to play videoPlayMuteCurrent Time 0:00/Duration 0:51Loaded: 11.78%0:00Stream Type LIVESeek to live, currently behind liveLIVERemaining Time -0:51 1xPlayback RateChaptersChaptersDescriptionsdescriptions off, selectedCaptionsCaptions off, selectedEnglishAudio Trackdefault, selectedFullscreenThis is a modal window. Why did you pick this product vs others?:Dual Lens Endoscope Camera with Light: Bought this to inspect a curved exhaust vent for my range hood. The dual camera setup (front and side views) works well. It’s easy to switch back and forth between cameras. I found that very helpful. You can see in the video at first I was using the front camera but because of the curve I the vent, the front camera was pushing up against the side of the vent. I switched to the side camera and that gave me the view that I needed. If you are trying to decide between single or dual lens, definitely get the dual lens!Android app is easy to use.Long cable gives plenty of reach. Decent image qualitySimple photo/video capture. Light provides good illumination.Minor note: Takes a few tries to navigate curves.Very satisfied with this purchase – would definitely recommend!